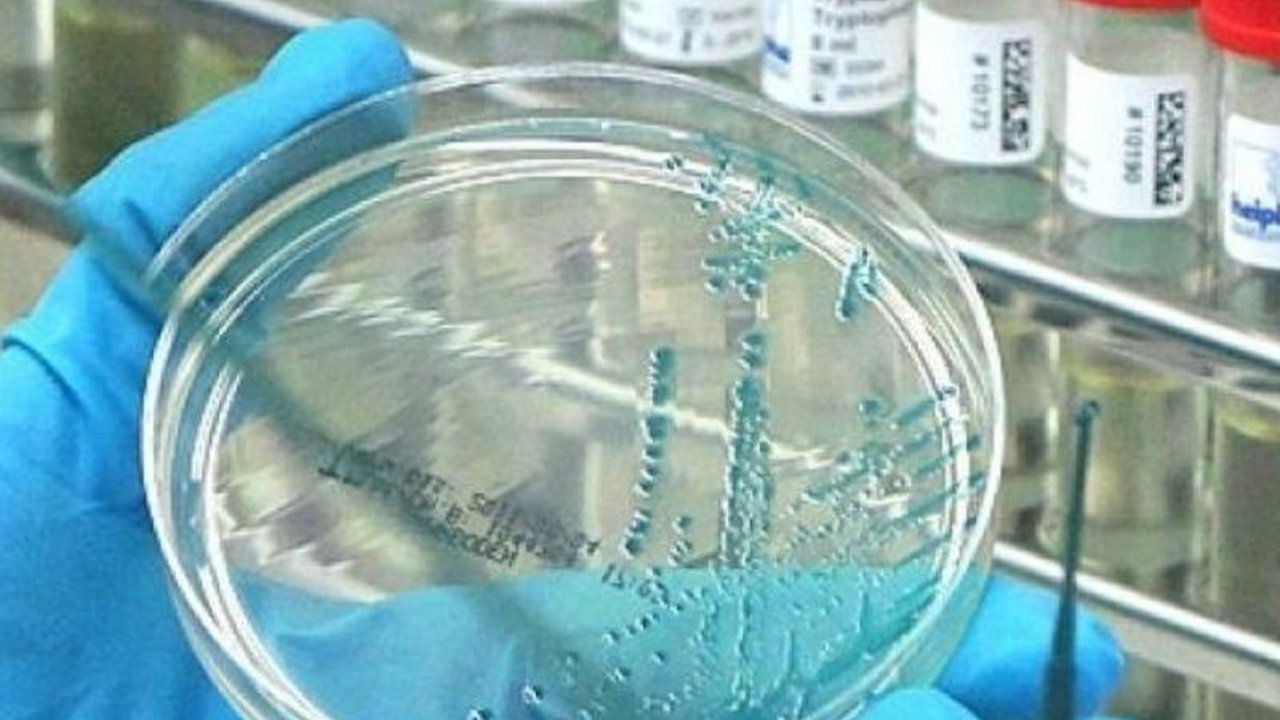
Badan Kesehatan Inggris mengkonfirmasi kasus infeksi flu burung A(H5N1) pada manusia di wilayah West Midlands, Inggris, dengan risiko penyebaran ke masyarakat luas dinilai sangat rendah.

Kasus Flu Burung Langka di Inggris: Satu Orang Terinfeksi, Risiko Penyebaran Rendah
Badan Kesehatan Inggris mengkonfirmasi kasus infeksi flu burung A(H5N1) pada manusia di wilayah West Midlands, Inggris, dengan risiko penyebaran ke masyarakat luas dinilai sangat rendah.
Sebuah kasus infeksi flu burung langka telah dikonfirmasi di Inggris. Badan Keamanan Kesehatan Inggris (UKHSA) mengumumkan pada Senin, 27 Januari 2024, bahwa seorang warga di wilayah West Midlands terinfeksi virus influenza A(H5N1).
Penularan terjadi di sebuah peternakan, di mana pasien melakukan kontak erat dengan sejumlah besar unggas yang terinfeksi dalam jangka waktu yang cukup lama. Ini merupakan kasus yang signifikan karena flu burung, atau avian influenza, biasanya menyerang unggas, dan penularan ke manusia relatif jarang.
Untungnya, pasien telah menerima perawatan intensif di unit khusus dan saat ini kondisinya dinyatakan baik. UKHSA menegaskan bahwa risiko penyebaran virus ke masyarakat luas dinilai sangat rendah. Hal ini memberikan sedikit kelegaan mengingat potensi penyebaran penyakit menular.
Virus yang terdeteksi adalah genotipe DI.2, yang saat ini beredar di antara populasi unggas di Inggris. UKHSA menekankan bahwa genotipe ini berbeda dari strain yang telah ditemukan pada mamalia dan burung di Amerika Serikat. Perbedaan ini penting untuk dipahami dalam upaya pencegahan dan pengendalian penyebaran lebih lanjut.
Organisasi Kesehatan Dunia (WHO) sebelumnya telah melaporkan deteksi strain flu burung H5 pada 76 orang sepanjang tahun 2024. Sebagian besar kasus, yaitu 61 orang, berasal dari kalangan petani di Amerika Serikat. Data ini menunjukkan pentingnya kewaspadaan dan tindakan pencegahan bagi mereka yang bekerja di sektor peternakan unggas.
Flu burung sendiri merupakan penyakit infeksi virus akut yang menyerang sistem pernapasan dan pencernaan unggas, dengan tingkat kematian yang tinggi. Burung migran, terutama bebek liar, diketahui sebagai pembawa virus ini dan memiliki daya tahan yang lebih baik dibandingkan unggas domestik. Namun, virus ini juga bisa menular pada manusia, meskipun kejadiannya masih jarang.
Kesimpulannya, meskipun kasus flu burung A(H5N1) pada manusia di Inggris ini menimbulkan kekhawatiran, otoritas kesehatan menekankan rendahnya risiko penyebaran ke masyarakat. Kejadian ini menyoroti pentingnya biosekuriti di peternakan unggas dan pemantauan kesehatan unggas secara ketat. Penelitian lebih lanjut tetap diperlukan untuk memahami lebih dalam mengenai dinamika penyebaran virus ini.